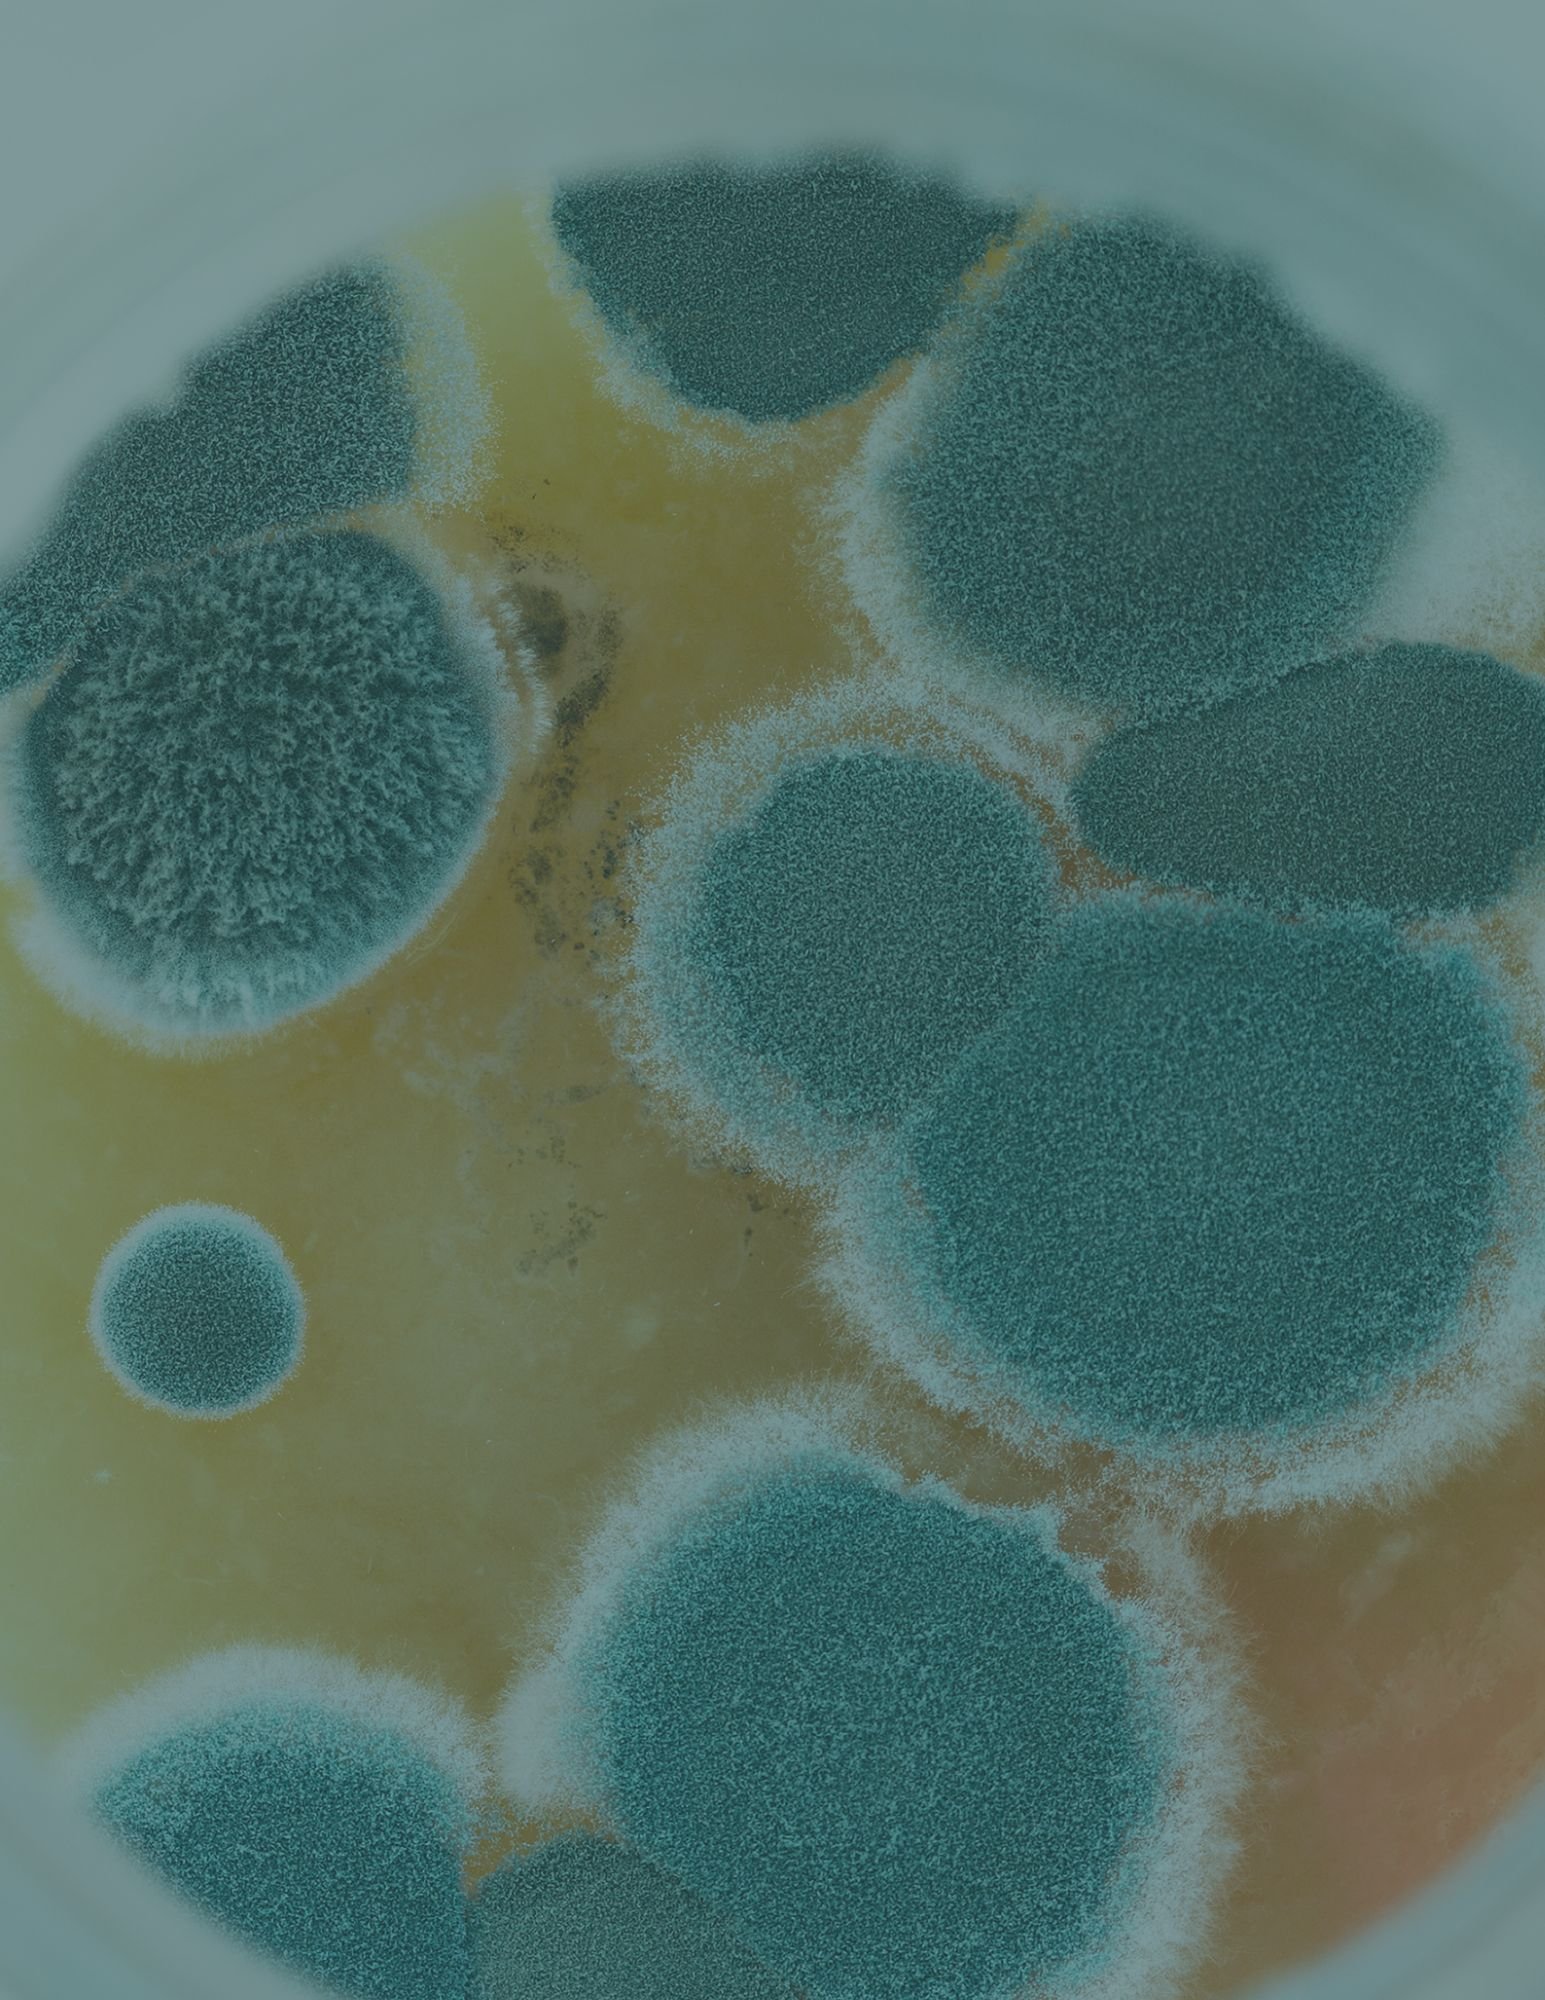

Weekly lifestyle newsletter
centered around gut & hormone health— for anyone wanting to simply improve these areas of their lives or facing their own health challenges.
Choose your free gift below and join the community.

Hi! I’m Carly, a Certified Holistic Health Coach.
My passion and purpose in this lifetime is to inspire others to lead a healthy lifestyle that supports their mind, body and spirit.
My mission is to help those struggling with gut and hormonal imbalances to overcome these challenges and live their best life yet.
If you are someone who could use some inspo’ or down right help in their health journey, check out the free resources below!
THE MINERAL MAP
REPLENISHMENT FOR STRESSED & SYMPTOMATIC WOMEN
A simple guide to help you understand what your body is asking for — and how to rebuild its deepest reserves.
Coming Soon.

Your body depends on minerals— yet deficiencies are at an all time high. Over 60% of reproductive-aged women are deficient in at least one micronutrient like iron, zinc and magnesium. This is the missing link to most health issues— AND why they keep coming back…
No one wants to find mold in their home.
But when I did, here are the steps I took.
I was in denial about the “dust” l saw on my ceiling being mold for far too long. I was terrified of the outcome if it was indeed mold. Would have to move? Condemn my home? Would cost me an arm and a leg to remediate?
Below is a free download to my personal story dealing with mold— from denying it’s existence, to testing, remediating and detoxing. If I can help just one person, then my job is done— because mold in your home, that’s no walk in the park.
But, it doesn’t have to be a daunting task. With the right testing, remediation and practitioner, you can recover from mold illness.

Wondering why you’re still dealing with acne?
I understand the mental, emotional & physical pain (not to mention confusion) you're experiencing because I've experienced it firsthand. It took me YEARS to heal my acne because I wasn’t uncovering the underlying root causes. Ever since, I've dedicated myself to guiding others facing the same challenge so that you don’t have to endure that painstaking timeline. I've put together a complimentary resource (did someone say f-r-e-e?!) for you to help you understand the WHY behind your unique case of acne. The goal of this free guide is to enlighten you with the tools you need to heal your acne for good. It provides a sneak peek into my approach with clients, where I help them uncover root causes & address them permanently so that they can achieve clear skin LONG TERM. My earnest goal is helping you embark on the journey of unraveling the mystery behind your acne, as I did for myself and as I have done for countless women like you.


My credentials:
BS Hospitality Management, Cum Laudi, FSU, Tallahassee, FL
Licensed Massage Therapist, The Salon Professional Academy, Melbourne, FL
Certified Holistic Health Coach, The Institute for Integrative Nutrition, NY
Hair Tissue Mineral Analysis, True Health Synergy by Maria Allerton
OAT Seminar, MosiacEDGE
GI MAP, GI MAP Deep Dive, 6 Week Course, Rupa Health
